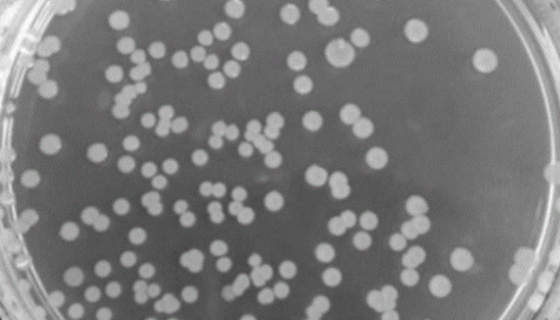
嗜热脂肪地芽胞杆菌的特点与功效及使用方法！
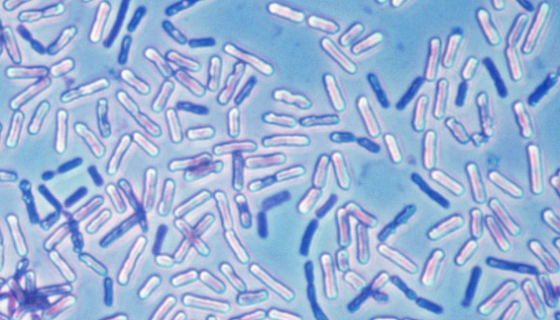
多粘类芽孢杆菌——主要用于抗真菌生防菌
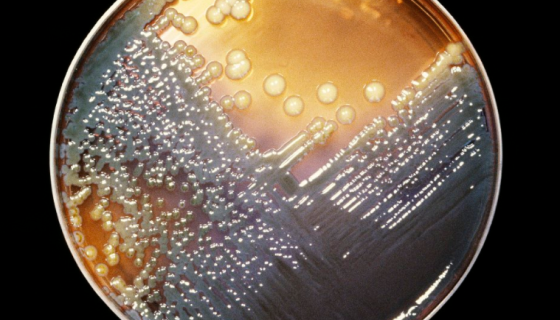
产气肠杆菌——用于教学与研究及异淀粉酶
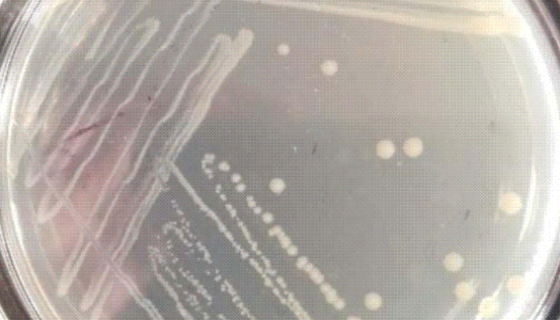
ATCC 11996 睾丸酮丛毛单胞菌 百欧博伟生物

嗜热脂肪地芽胞杆菌的特点与功效及使用方法!
嗜热脂肪地芽胞杆菌(Bacillusstearothermo...

ATCC 19622 地分枝杆菌的复壮方法与操作流程!
地分枝杆菌的复壮方法与操作流程。
多粘类芽孢杆菌——主要用于抗真菌生防菌
多粘类芽孢杆菌(Paenibacillus polymyxa...

Kelly人神经母细胞瘤细胞的培养方式与质量检测!
人神经母细胞瘤细胞的培养方式与质量检测及注意事项有哪些?

ATCC 11442 噬组氨醇节杆菌 百欧博伟生物
ATCC 11442 噬组氨醇节杆菌知识解析。

可可球二孢的特点与优势及微生物培养方法!
可可球二孢是Lasiodiplodia属的微生物,原产地为中...
产气肠杆菌——用于教学与研究及异淀粉酶
产气肠杆菌(Enterobacter aerogenes)系...

人NK/T细胞淋巴瘤细胞的处理方法与培养步骤!
NK/T细胞淋巴瘤(NK/T cell lymphoma)是...
ATCC 11996 睾丸酮丛毛单胞菌 百欧博伟生物
睾丸酮丛毛单胞菌(comamonastrstosteroni...